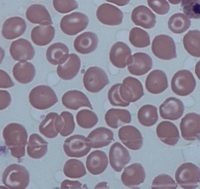
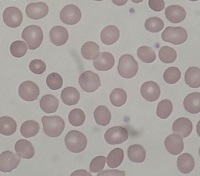
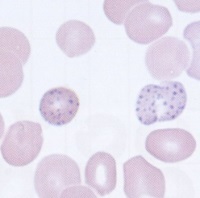

1
Q
Abnormality - Target Cell
- Sickle-cell/thalassaemia
- Iron-deficiency anaemia
- Hyposplenism
- Liver disease
A
2
Q
Abnormality - ‘Tear-drop’ poikilocytes’
- Myelofibrosis
A

3
Q
Spherocytes:
- Hereditary spherocytosis
- Autoimmune hemolytic anaemia
A
4
Q
Basophilic stippling:
- Lead poisoning
- Thalassaemia
- Sideroblastic anemia
- Myelodysplasia
A
5
Q
A


